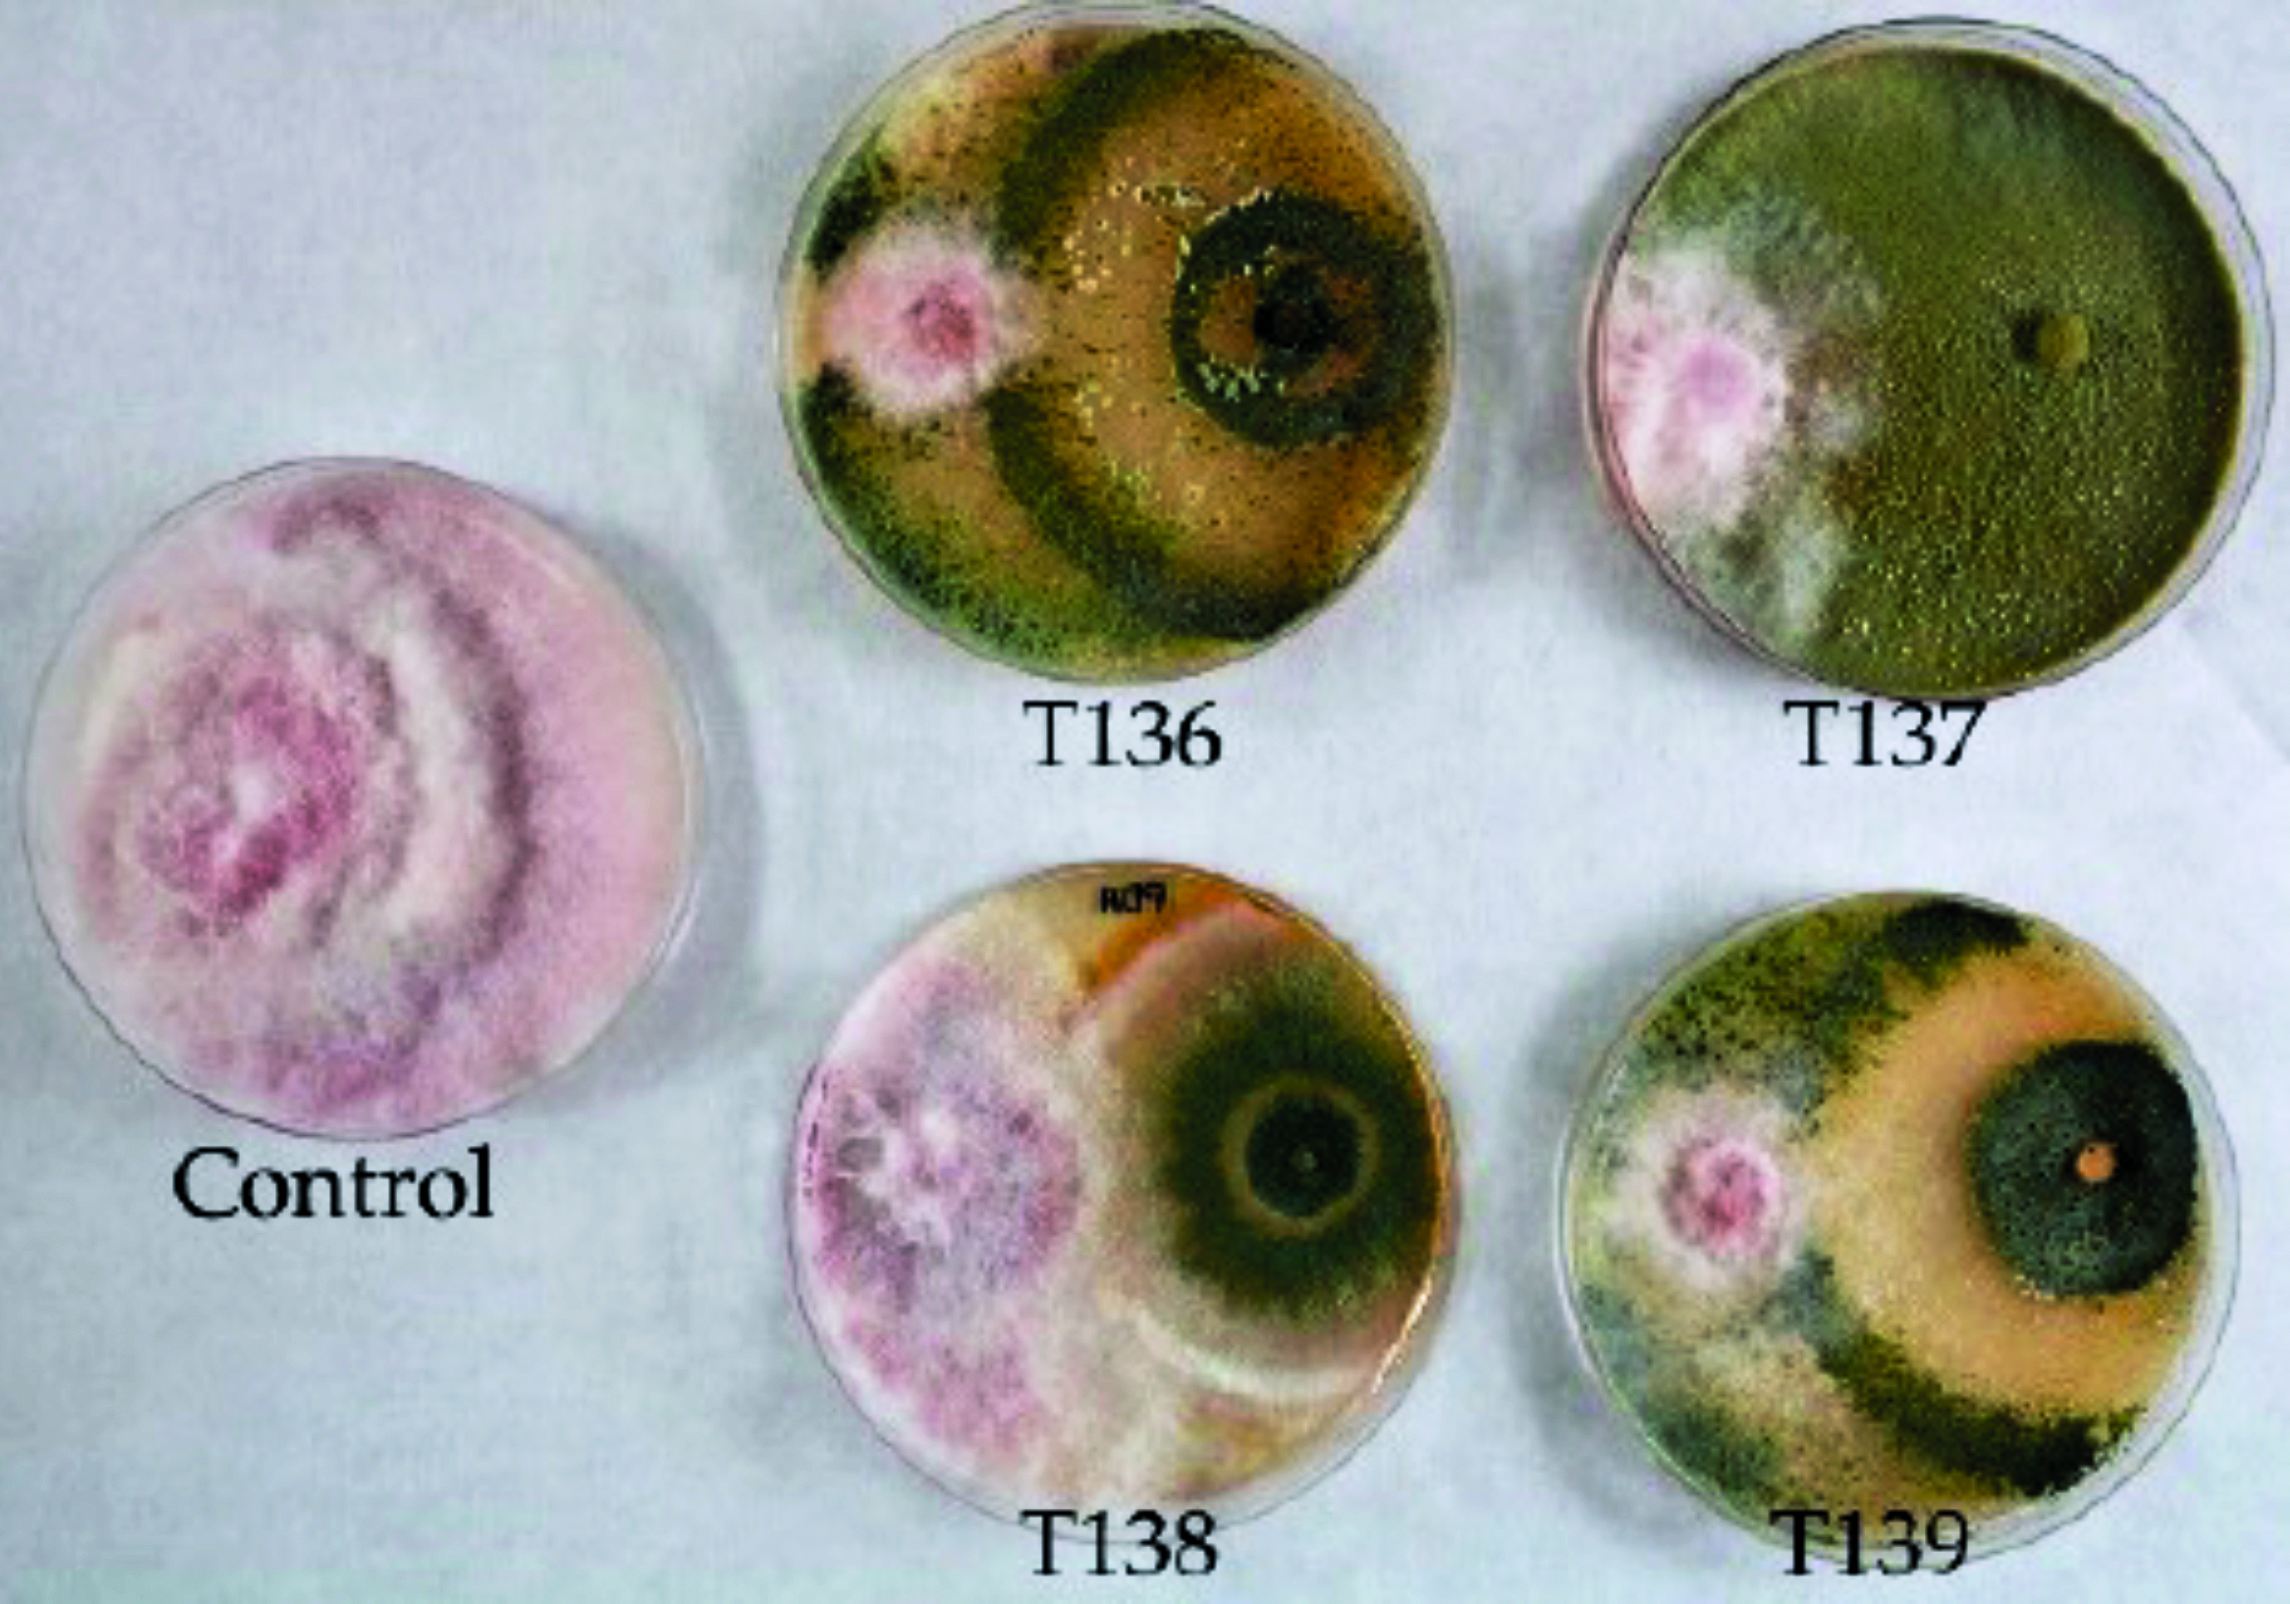

Solución Agrotareo: una oportunidad para ahorrar millones
Agrotareo es una solución tecnológica de trazabilidad de los trabajadores en el campo que propicia importantes ahorros de costos durante la campaña.
Desde hace más de tres décadas, Hispatec se dedica a desarrollar soluciones tecnológicas para empresas agrícolas. Hoy está en más de 25 países y con oficinas propias en España, Chile, Perú y México con un staff de más de 170 profesionales. Este crecimiento les ha permitido trabajar en proyectos en los cinco continentes. Hoy, el grupo está conformado por tres empresas: Hispatec Agrointeligencia (que desarrolla el software del conglomerado), Hispatec Analytics (que utiliza el big data para ofrecer diferentes paneles de predicción de cosechas, predicción de plagas, etc.) e Hispatec Track (que monitorea los contenedores de productos agrícolas a través de GPS).
“Uno de los principales desafíos de las empresas agrícolas es calcular cuál va a ser su cosecha, porque en base a eso diseñan su programa de comercialización. Puede ser una gran pérdida cosechar menos e incluso más de lo proyectado, porque eso modifica los acuerdos con los clientes o hacer una venta con un precio muy por debajo de lo mercado”, explica el gerente general de Hispatec Perú, Jaime Sánchez. A través de un ERP (Enterprise Resource Planning, por sus siglas en inglés, un sistema integral parecido a SAP, pero enfocado en agro), Hispatec gestiona digitalmente todas las partes de una empresa Agroexportadora: la producción en vivero, semillero y campo, el packing de la fruta y su transformación, y la logística y comercialización.
Hispatec, un aliado de importantes agroexportadoras
Además de Camposol, Hispatec cuenta con una gran cartera de clientes en Latinoamérica y todo el mundo como son Sun Fruit, Agrícola Cerro Prieto, Green Superfoods, San José Farms, etc. Asimismo, el sistema es usado por un gran número de agroexportadoras en Chile, Colombia, México y Brasil.

UN AHORRO IMPORTANTE
Uno de los principales problemas de las empresas agrícolas es el control de los trabajadores en el campo. Para solucionarlo, Hispatec ha creado Agrotareo: un software que permite controlar digitalmente la trazabilidad de los trabajadores desde que suben a las movilidades que los traslada al campo, hasta el cobro de sus productividades.
“Esta trazabilidad es importante porque cultivos como la palta, el arándano o la uva requieren de miles de trabajadores al mismo tiempo en el campo, y es muy difícil calcular cuántas horas han trabajado, si hay que pagarles bonos o no, cuánto han cosechado para pagar liquidaciones… Tengamos en cuenta que entre el 30 o 40% del gasto de una empresa agrícola son los trabajadores. Y si te equivocas en un 1% en una empresa que factura US$100 millones, pues te estás equivocando en US$1 millón”, expone Sánchez. Con Agrotareo es posible digitalizar:
Transporte: El chofer del bus escanea un código de barras o QR de los fotocheck de los trabajadores que va a llevar al campo. En el momento que suben, el sistema informa al conductor si el agricultor está autorizado a entrar o no, si recién va a buscar trabajo, si está de baja o de vacaciones, y en tal caso no le deja subir.
Una vez que ya se ha escaneado, empieza la trazabilidad de los trabajadores. Hay empresas que utilizan 500 autobuses todos los días, como es el caso de Camposol, uno de los clientes peruanos más grandes de Hispatec. “Saber la cantidad de pasajeros también permite gestionar mejor los autobuses, con lo cual nuestras empresas han ahorrado más de un 20% en transporte con nuestro sistema, solo dando información de dónde sube cada uno de los trabajadores”, comenta Jaime Sánchez.
Cuando llegan al fundo, los trabajadores ya no tienen que identificarse uno por uno, sino que se escanea el código del chofer y automáticamente se descarga el manifiesto con los datos de todos los pasajeros. “Así te ahorras en la entrada mucho tiempo. . Por ejemplo, 10,000 trabajadores en época de cosecha que cobran 50 soles el día. Estamos hablando 500,000 soles al día en jornales. Cada minuto perdido, se pierde mucho dinero” observa Sánchez.
Acceso: Los trabajadores entran en el fundo sin demoras ni cuellos de botella. Se cambian de ropa, recogen sus herramientas e inmediatamente comienzan a trabajar.
Actividad de campo: El jefe de cuadrilla suele emplear siempre a los mismos trabajadores, pero también tiene información por si quiere conformar de manera diferente sus cuadrillas y emplear a unos y otros para tal o cual labor. “Tengamos en cuenta que todas las labores se pagan diferente: cosecha, limpieza, corte, etc. A través de nuestro sistema, se puede controlar qué trabajador ha hecho cada actividad y va calculando los costos asociados a cada trabajador”, comenta Jaime Sánchez.
Productividad: Agrotareo permite ir controlando la productividad individual de los trabajadores o las cuadrillas simplemente escaneando los códigos de cada trabajador mientras van trayendo la fruta, pudiendo mandar un reporte al mismo trabajador al terminar las jornadas.
Solicitud: En la organización tradicional del campo, cada vez que el jefe de cuadrilla tenía alguna necesidad debía llamar a su jefe, este consultaba a su superior, y así sucesivamente en toda la cadena de mando, por ejemplo, “necesitamos dos horas más de trabajo porque no estamos terminando a tiempo”. Desde ahora, eso se puede hacer desde el celular, y va apareciendo de manera automática en la aplicación si sus superiores han aceptado la solicitud o no.
Planillas: Antes, esa tarea la realizaba una persona en campo anotando en un papel, que luego pasaba a varios supervisores hasta que llegaba a Recursos Humanos. ”Se perdía mucha información y había muchos errores. Con Agrotareo se evitan todos esos problemas, y se ahorra mucho dinero. Por ejemplo, clientes de Hispatec que usan su aplicación, han ahorrado entre el 2-7% de costos de producción”, declara Sánchez.
